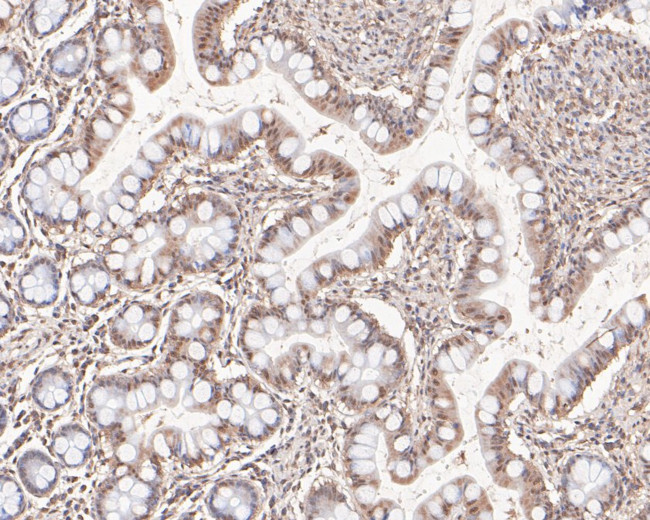
HNF1 alpha Antibody in Immunohistochemistry (Paraffin) (IHC (P))

Search
Huabio
HNF1 alpha Polyclonal Antibody
{{$productOrderCtrl.translations['antibody.pdp.commerceCard.promotion.promotions']}}
{{$productOrderCtrl.translations['antibody.pdp.commerceCard.promotion.viewpromo']}}
{{$productOrderCtrl.translations['antibody.pdp.commerceCard.promotion.promocode']}}: {{promo.promoCode}} {{promo.promoTitle}} {{promo.promoDescription}}. {{$productOrderCtrl.translations['antibody.pdp.commerceCard.promotion.learnmore']}}
图: 1 / 5
HNF1 alpha Antibody (HA500285) in IHC (P)





产品信息
HA500285
种属反应
宿主/亚型
分类
类型
抗原
偶联物
形式
浓度
规格
纯化类型
保存液
内含物
保存条件
运输条件
靶标信息
This gene is expressed ubiquitously with higher levels in fetal than in adult tissues. It encodes a protein sharing 93% sequence identity with the mouse protein. Wolf-Hirschhorn syndrome (WHS) is a malformation syndrome associated with a hemizygous deletion of the distal short arm of chromosome 4. This gene is mapped to the 165 kb WHS critical region, and may play a role in the phenotype of the WHS or Pitt-Rogers-Danks syndrome. The encoded protein is found to be capable of reacting with HLA-A2-restricted and tumor-specific cytotoxic T lymphocytes, suggesting a target for use in specific immunotherapy for a large number of cancer patients. This protein has also been shown to be a member of the NELF (negative elongation factor) protein complex that participates in the regulation of RNA polymerase II transcription elongation.
仅用于科研。不用于诊断过程。未经明确授权不得转售。
篇参考文献 (0)
生物信息学
蛋白别名: albumin proximal factor; hepatic nuclear factor 1; hepatic nuclear factor-1-alpha; hepatocyte nuclear factor 1; Hepatocyte nuclear factor 1-alpha; hnf-1 alpha; HNF-1-alpha; HNF-1A; interferon production regulator factor; LF-B1 hepatic nuclear factor (HNF1): albumin proximal factor also TCF1; LF-B1, hepatic nuclear factor (HNF1): albumin proximal factor, also TCF1; LFB1; Liver-specific transcription factor LF-B1; TCF-1; transcription factor; Transcription factor 1; Transcription factor 1 hepatic; Transcription factor 1, hepatic; unnamed protein product
基因别名: AI323641; Hnf-1; HNF-1-alpha; HNF-1A; HNF1; HNF1-alpha; HNF1[a]; HNF1A; HNF1alpha; HNF4A; IDDM20; LF-B1; LFB1; MODY3; TCF-1; TCF1
UniProt ID: (Human) P20823, (Rat) P15257, (Mouse) P22361
Entrez Gene ID: (Human) 6927, (Rat) 24817, (Mouse) 21405